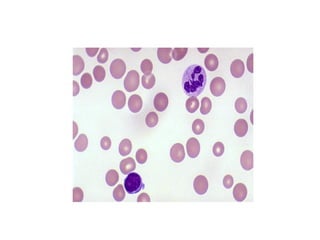

- Anemia is caused by decreased oxygen carrying capacity leading to tissue hypoxia. The body attempts to compensate through various mechanisms but these eventually fail as hypoxia worsens.
- Symptoms of anemia are due to tissue hypoxia and the body's compensatory responses, and include pallor, weakness, breathlessness, palpitations, headaches, and gastrointestinal issues.
- Iron deficiency anemia is the most common type of anemia globally. It results from inadequate iron intake, increased losses, or poor absorption and leads to microcytic hypochromic anemia.